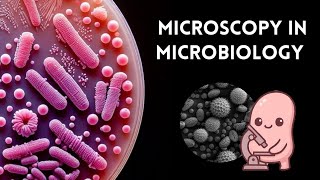

Welcome to Medulla Tales!✨
I’m Ayesha, a 3rd-year MBBS student from India, passionate about breaking down complex medical concepts into simple, easy-to-understand lessons.
On this channel, you’ll find:
📌 Simplified explanations of Microbiology, Pathology, Pharmacology, Histology, Forensic Medicine and others
📌 Concept-based learning for MBBS students and medical aspirants
📌 Tips, tricks, and notes to help you study smarter, not harder
I’m also building a website where I’ll share my personal notes and resources.
If you’re a medical student or just curious about how the human body and diseases work, hit subscribe and join me on this journey of learning medicine the easy way!
Shared 5 months ago
119 views
Shared 5 months ago
157 views
Shared 6 months ago
304 views
Shared 6 months ago
467 views